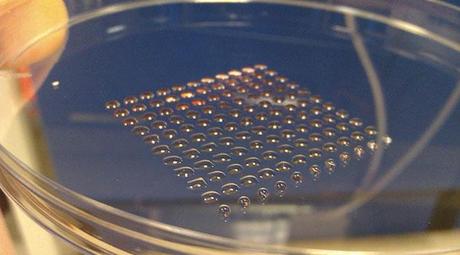
Le Tecnologie più Attese del 2014 Le Tecnologie più Attese del 2014

Uno sguardo all'hardware PC del 2014, insostituibile trampolino di lancio per innumerevoli tecnologie
Il 2014 è davanti a noi e sarà un anno molto importante per il PC. Ci troviamo, infatti, di fronte a uno stacco evolutivo che include una maggiore ottimizzazione del software, distribuzione digitale avanzata e una semplicità di sviluppo sempre maggiore. Armi con cui il computer intende sfidare sia i tablet sia le console classiche che potrebbero trovare un pericoloso e inatteso concorrente nelle Steam Machines di Valve. Inoltre, il PC sarà il primo a poter fruire di videogiochi in risoluzione 4K e, cosa ancora più importante, dei visori 3D che promettono un balzo in avanti netto in termini di immersività. Balzo che avverrà, quasi sicuramente, in progetti come Star Citizen, indipendenti e resi forti da un immenso quantitativo di finanziamenti dal basso, ma che potrebbe non toccare a molti multipiattaforma, probabilmente destinati a essere frenati dalla necessità di bilanciare le esigenze della versione console e di quella PC.
AMD punta sul compatto e sul software
Una AMD cosi impegnata non la si vedeva da tempo tra sistemi basati su processori ARM, nuove APU sempre più potenti, librerie che promettono miracoli, l'impegno sui chipset per Xbox One e PlayStation 4 e i lavori su un nuovo processore desktop che dovrebbe riportare la compagnia in carreggiata nel settore che l'ha lanciata. Ma proprio quest'ultimo campo potrebbe rimanere scoperto, almeno nel corso del 2014, stando a quanto affermano alcuni rumor apparentemente confermati da una roadmap comparsa recentemente nella rete. Secondo le indiscrezioni, le CPU basate su tecnologia Steamroller, quella alla base delle APU Kaveri che garantisce una resa maggiore per singolo core e sfrutta un quantitativo maggiore di memoria cache, potrebbero arrivare addirittura nel 2015. Dunque, se la roadmap di AMD venisse confermata ci troveremmo di fronte a un rinvio di oltre un anno presumibilmente dovuto all'impegno sulle APU per le console di nuova generazione e su quelle per sistemi mobile e soluzioni compatte. Ma d'altronde AMD ha dimostrato di credere fermamente in quest'ambito che ha ricompensato gli sforzi dell'azienda mantenendola a galla in un periodo non facilissimo. Eppure, rinunciare alle nuove CPU desktop e relegare la tecnologia Steamroller alla sola APU Kaveri significa mollare la presa sul mercato dei PC classici, server inclusi, e lasciare spazio a una Intel già preponderante. Una mossa pericolosa per quanto AMD sembri convinta che le prossime APU, grazie alla combinazione tra le tecnolgie GCN e Steamroller, saranno capaci addirittura di avvicinarsi, in termini prestazionali, ai sistemi classici, quelli composti da CPU massiccia e GPU discreta. E la compagnia statunitense potrebbe non avere tutti i torti, almeno in relazione alle richieste hardware medie dei titoli in arrivo, visto che le console detteranno il passo, almeno per un paio di anni, in molti dei titoli multipiattaforma castrando, come al solito, le configurazioni PC di fascia alta. Ma queste non rappresentano il grosso del mercato e con l'arrivo delle Steam Machines, che per chi ancora non lo sapesse sono PC compatti e facilmente upgradabili uniti ad un sistema operativo creato ad hoc, il mercato PC potrebbe espandersi laddove nessuno se lo aspettava ovvero nella fascia media. Ci saranno Steam Machine da 1500 euro, è chiaro, ma tra SteamOS, le librerie Mantle di AMD e le nuove PhysX, la promessa per il prossimo anno è quella di uno sfruttamento maggiore dell'hardware. Sfruttamento che dovrebbe estendersi ai porting da console vista la somiglianza tra l'hardware di queste ultime e quello per PC. Dunque, invece di vedere un porting scattare su una macchina decine di volte più potente di quella per cui il titolo in questione è stato sviluppato, potremmo finalmente vedere PC di fascia media capaci di far girare agilmente un qualsivoglia multipiattaforma. Speriamo bene.
L'ottimizzazione è il sale della vita
Come dicevamo, la risposta di Nvidia alle nuove librerie AMD, quelle Mantle che promettono una programmazione di basso livello agile e accessibile, è un potenziamento generale delle PhysX sia dal punto di vista dell'ottimizzazione che da quello delle feature. Queste ultime comprendono una simulazione realistica dei capelli, che in casa AMD hanno già la loro libreria dedicata, e la possibilità di combinare i diversi effetti della fisica andando a creare fenomeni estremamente complessi (es. detriti che volano in acqua creando centinaia di onde). E il tutto, almeno su carta, senza un incremento eccessivo nelle richieste hardware. Di fronte a questo tipo di evoluzione è chiaro che non c'è bisogno, almeno in ambito gaming, di CPU più potenti di quelle attuali anche se, questo è ovvio, il rinnovamento e i miglioramenti in termini di consumo e calore sono comunque bene accetti e mantengono vivo il mercato. In ogni caso, pur non ritardando quanto AMD, Intel se la prenderà comoda e aspetterà fino alla fine del prossimo anno per presentare le sue nuove CPU che saranno sempre della famiglia Haswell. Le nuove versioni del processore, questo è inevitabile, non punteranno a stravolgere il mondo ma d'altronde le CPU Ivy Bridge hanno già introdotto parecchie novità, come il triplo gate per ogni transistor, che sono ancora da sfruttare a pieno. Dunque i nuovi Haswell continueranno sulla strada dell'ottimizzazione per essere utilizzabili sia in soluzioni desktop sia all'interno di ultrabook e portatili di piccole dimensioni. Processori classici, sempre integrati con una GPU, capaci di essere concorrenti sia per le APU sia per i futuri Opteron basati su tecnologia Steamroller. E nel 2015 le cose non dovrebbero accelerare particolarmente con Intel che, almeno pubblicamente, ha annunciato solo l'arrivo dei processori Broadwell-K, le CPU dedicate agli amanti dell'overclocking. Intel, in sostanza, non sembra spaventata dalle nuove APU anche se AMD sta riscontrando un ottimo successo in questo campo. Ma non possiamo non notare che l'offerta del 2014, escludendo Kaveri, è fatta di soluzioni ottenute da tecnolgie precedenti. Temash, infatti, è un derivato del Jaguar che fa da cervello centrale per PS4 e Xbox One mentre il chipset Brazos 2.0 è composto da un doppio Bobcat affiancato con una GPU DX11 di fascia bassa.
Verso i 20 nanometri
Ricapitolando, il grosso del movimento evolutivo delle tecnologie classiche, al momento, gira sul software e sulle soluzioni a risparmio energetico e anche nel campo delle schede video le strategie a breve termine prevedono revisioni, potenziamenti e versioni potenziate delle tecnologie già esistenti. La R9 290 introduce qualche piccola novità ma non ci sono stravolgimenti e non a caso la GTX 780 Ti e la revisione della Titan, per ora ancora nel limbo, sono le uniche risposte, escludendo un taglio dei prezzi di listino, da parte di Nvidia per la concorrente diretta. Per vedere qualcosa di nuovo, almeno in casa Nvidia, sarà necessario aspettare la seconda metà del 2014 e le nuove GPU saranno, presumibilmente, a 20 nanometri. Anche AMD sta seguendo, inevitabilmente, quella strada ma non si è lasciata scappare alcuna indiscrezione sulla finestra di presentazione della prossima serie mentre Maxwell uscirà indubbiamente nella seconda metà del 2014 visto che a metà del prossimo anno ci sarà un'ulteriore revisione delle schede Nvidia basate su tecnologia Kepler. Ovviamente il calendario di Nvidia non è casuale e le tempistiche dovrebbero coincidere con la possibilità di TSMC di lavorare con il processo produttivo a 20 nanometri. Purtroppo non è detto che il colosso dei semiconduttori sia in grado di rispettare le scadenze, tanto più che in passato si è concesso rinvii in più occasioni, e questo potrebbe tradursi nell'arrivo di GPU Maxwell a 28nm, cosa che frenerebbe la corsa all'ottimizzazione di temperature e consumi, ma è più probabile che Nvidia decida di rinviare visto che progettare una GPU per due processi produttivi differenti sarebbe molto, molto costoso. Tanto più se si tratta di un chip sperimentale. Maxwell, infatti, dovrebbe integrare un processore ARM a 64 bit capace di rendere le nuove schede video autonome, capaci di avviare un sistema senza il bisogno di una CPU. Teoricamente stiamo parlando di APU ultracompatte basate su tecnologia ARM ma i dati in nostro possesso sono pressochè nulli ed è davvero troppo presto per fare ipotesi. Insomma, il panorama hardware ci propone ben poche certezze e ci riserva il solito marasma di voci e promesse che difficilmente si tradurranno in rivoluzioni. Ma il panorama tecnologico è fatto anche di piccoli avanzamenti che non sono poi tanto piccoli se parliamo di ampliare, finalmente, la banda passante della memoria dei nostri PC. Mentre PS4 è passata alle DDR5, per il PC si parla di moduli DDR4 che, nonostante il numerino inferiore, implicano un netto aumento in termini di densità, superiore del 300% rispetto alla memoria DDR3, e di velocità, fattore che su carta risulta raddoppiato anche in relazione ai tempi di accesso. A quanto pare, inoltre, i banchi di memoria partiranno dalla dimensione di 4GB e la velocità andrà da un minimo di 2133MHz a un massimo di 4266MHz. Supportata dalle schede madre Haswell, la memoria non è compatibile con i PC legati a tecnologie precedenti e non arriverà in casa AMD fino a metà 2014, quando la compagnia rilascerà il SoC ARM Hierofalcon. Nel medesimo periodo il mondo delle memorie andrà incontro a un'altra rivoluzione, sempre che Intel non vada incontro a ritardi, con l'arrivo delle prime SSD da 2TB. Parliamo della serie Intel DC P3700, inevitabilmente di fascia alta, che promette anche performance di alto livello con una velocità di 2800/1700MBps per quanto riguarda, rispettivamente, lettura e scrittura sequenziali.
Nuovi orizzonti
Anche se dal punto di vista delle schede video e dei processori il futuro non appare esaltante, benchè in relazione alle GPU si tenda sempre a mantenere il segreto fino all'ultimo momento, l'evoluzione tecnologica non è confinata alle sole tecnologie mobile. Il 2014, infatti, sarà l'anno dei visori e dei monitor 4K che, in combinazione con un rinnovato interesse per l'ottimizzazione, dovrebbero finalmente spremere a fondo i potenti PC che già albergano nelle nostre case. Dei due, il visore 3D è inevitabilmente il più interessante visto che porta con sé il sogno, uno dei più vecchi del mondo dell'entertainment, dell'avvento della realtà virtuale e non a caso la concorrenza è già alle stelle nonostante non ci sia ancora un visore tridimensionale disponibile in versione definitiva. Il Sony HMZ-T3W di Sony, infatti, si limita a simulare l'effetto 3D già fruibile al cinema, sulla TV o su PC con gli appositi occhiali. Ma Oculus Rift, il cui kit di sviluppo è già acquistabile, dovrebbe essere in dirittura d'arrivo anche grazie a un finanziamento da 75 milioni di dollari che sottolinea più di mille parole l'interesse del mercato verso questa nuova tecnologia. E anche Valve ha un visore in lavorazione che verrà presumibilmente svelato una volta lanciate le Steam Machines. Entrambe sono state anticipate da un concorrente a sorpresa che con un visore Glyph, mostrato a pochi fortunati, non ha copiato l'Oculus Rift, unico visore acquistabile sebbene in versione ancora non definitiva, ma ha tentato una strada alternativa fatta di milioni di specchietti che riflettono i punti dell'immagine direttamente nell'occhio di chi indossa il caschetto. Non sappiamo quanto bene funzioni questa tecnologia, mentre l'Oculus Rift ha dato prova di essere fruibile nonostante ci siano da risolvere alcuni problemi, ma se non altro sappiamo che riduce le dimensioni dello strumento con il Glyph che risulta decisamente più contenuto del Rift e si permette anche di integrare una grossa cuffia utilizzabile in modo indipendente dal visore.

